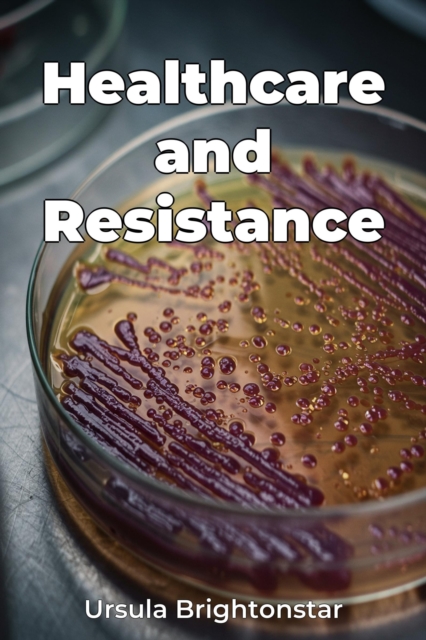
Healthcare and Resistance

Healthcare and Resistance
Healthcare-associated infections (HAIs) are an increasing threat, fueled by antibiotic resistance. Healthcare and Resistance addresses this urgent issue, exploring the mechanisms behind resistance, the epidemiology of HAIs, and strategies for prevention. Understanding bacterial evolution and its impact is paramount, as the book details how pathogens evade antimicrobial drugs. The rise in resistant...
Healthcare-associated infections (HAIs) are an increasing threat, fueled by antibiotic resistance. Healthcare and Resistance addresses this urgent issue, exploring the mechanisms behind resistance, the epidemiology of HAIs, and strategies for prevention. Understanding bacterial evolution and its impact is paramount, as the book details how pathogens evade antimicrobial drugs. The rise in resistant...
